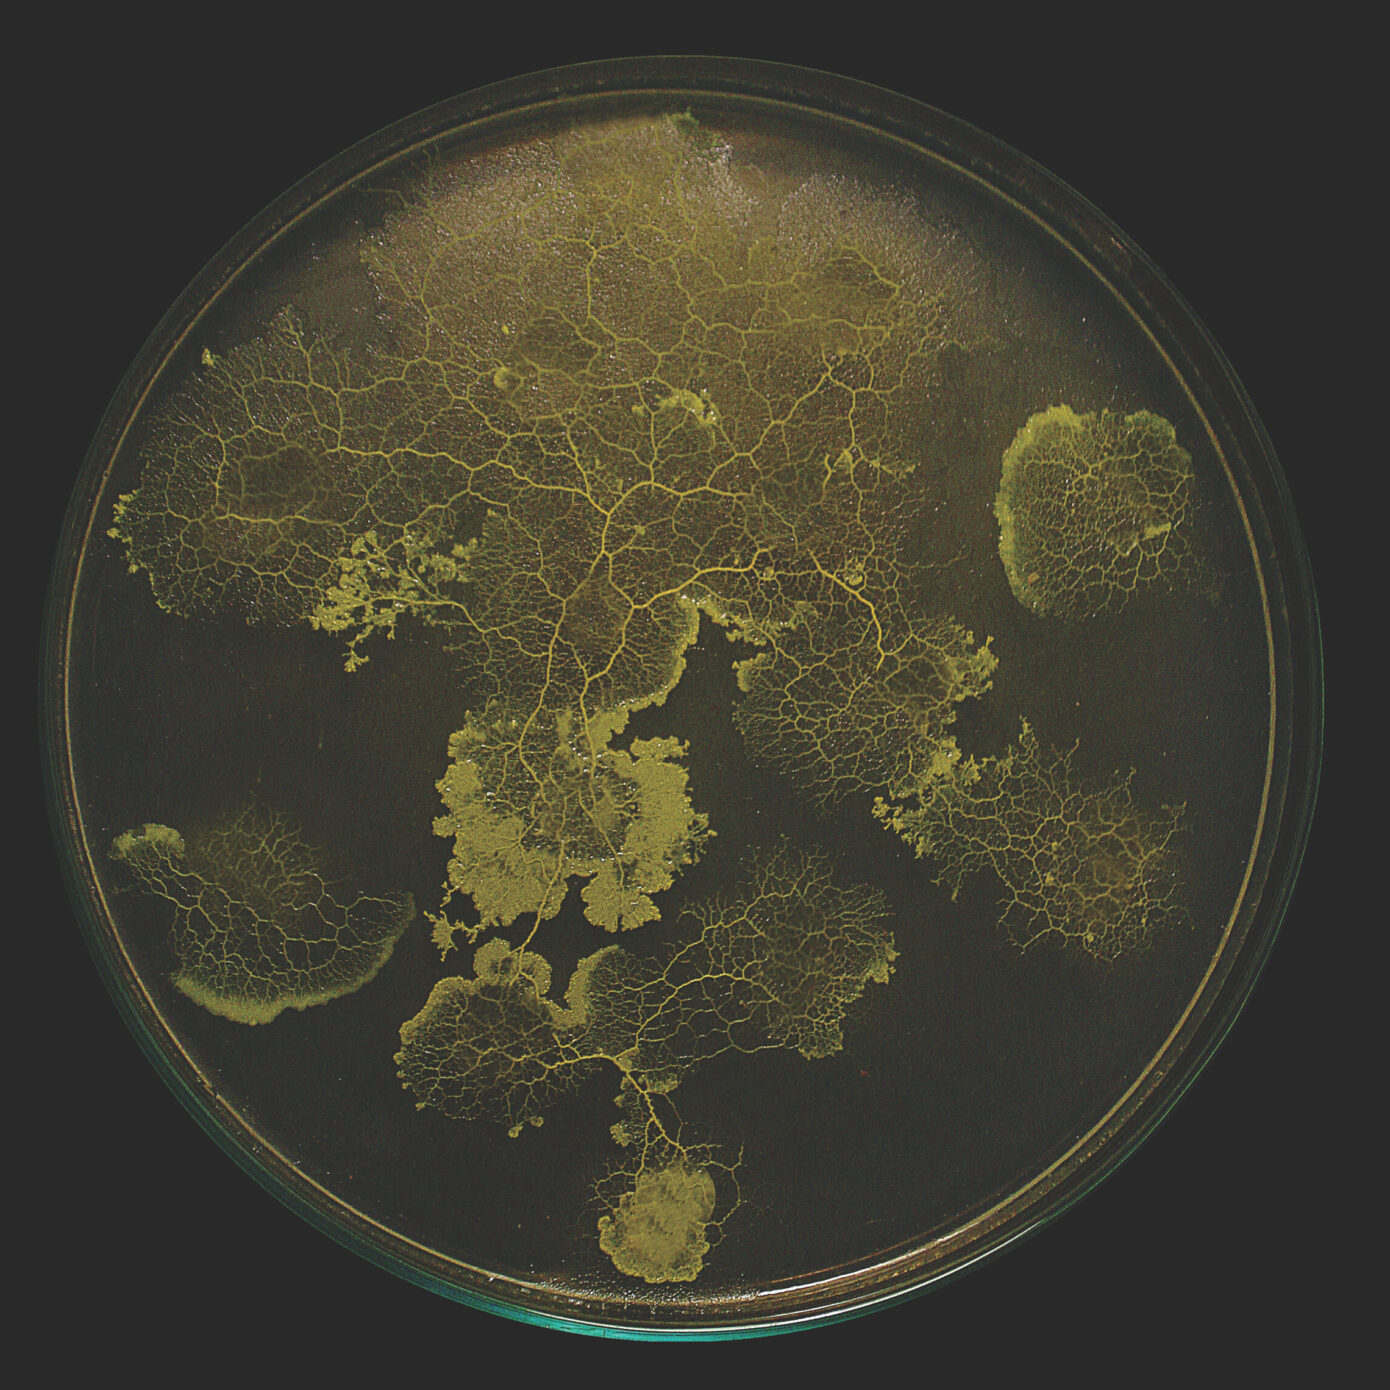

Design vivant : vers de nouveaux artefacts

- Publié le 11 juillet 2021
- Marie-Ange Brayer
- 7 minutes
Face aux enjeux écologiques, les designers explorent de nouveaux matériaux capables de remplacer le plastique. Biodégradables, renouvelables, bio-composés, à croissance autonome… Découvrez trois projets prototypes.
Les technologies numériques ont entraîné un changement de paradigme, estompant les frontières entre réel et virtuel, organique et artificiel, matériel et immatériel. Dès les années 1960, dans le sillage de la cybernétique, les artistes intègrent des micro-organismes dans leurs œuvres. Depuis la prise de conscience globale des enjeux écologiques, designers ou architectes se sont emparés de l’intelligence du vivant (micro-organismes, mycélium de champignon, algues, bactéries, « blob » ou physarum polycephalum, etc.). Ils se tournent vers la conception de nouveaux artefacts durables, objets hybrides entre fabrication numérique et exploration des ressources de la nature. Leur démarche s’inscrit dans une recherche d’alternatives aux matériaux polluants ou encore, dans le champ d’applications environnementales à l’échelle de l’architecture ou de la ville.
Marie-Ange Brayer, conservatrice et cheffe du service Design et Prospective industrielle au Mnam-Cci, Centre Pompidou, nous donne un aperçu des formes de collaborations possibles entre technologies numériques et intelligence de la nature, au travers de trois projets, illustrant un nouveau rapport au vivant. Un extrait en avant-première de son article prévu dans le 5e numéro de notre revue Stream, à paraître cet automne.
Imprimer de la matière biologique
« Un exemple d’innovation qui croise les technologies numériques et l’intelligence du vivant est la Mycélium Chair (2018) de Klarenbeek & Dros, studio néerlandais de design. Cette œuvre, présente dans les collections du Centre Pompidou, est issue d’une nouvelle technologie d’impression 3D de mycélium vivant, développée depuis 2011 par ces designers, dans une recherche d’alternative industrielle aux plastiques et aux bioplastiques. Klarenbeek & Dros s’intéressent également aux algues comme nouveaux matériaux novateurs. Les matériaux traditionnels de production sont ici remplacés par une matière vivante. Cette chaise est faite à partir d’une structure imprimée en 3D, dans laquelle se développe le mycélium vivant d’un champignon (le reishi, un champignon particulièrement résistant), imprimé numériquement dans un mélange d’eau, de paille en poudre et de sciure. Le mycélium fait ici office de ‘‘colle vivante’’. Une fois imprimée, cette chaise ‘‘vivante’’, avec ses champignons, continue de croître quelques jours en laboratoire. Une fine couche de bioplastique vient ensuite la recouvrir afin de stopper le processus de croissance. La chaise peut être compostée et ce procédé pourrait trouver de nombreuses autres applications dans les produits de la vie quotidienne. »


Concevoir des matériaux intelligents
« Designer et ingénieure, directrice de laboratoire au MIT, Neri Oxman croise, depuis le début du numérique, biodesign et informatique. Avec le projet Aguahoja, présenté dans l’exposition ‘‘La Fabrique du vivant’’M.-A. Brayer, O. Zeitoun (dir.), La Fabrique du vivant, éd. HYX & éd. du Centre Pompidou, 2019., en 2019, au Centre Pompidou, dont j’étais commissaire avec Olivier Zeitoun, elle exposa des objets bio-composites, résultat d’une fabrication numérique, tout en s’inspirant des propriétés de la nature. À mi-chemin entre le vivant et l’artificiel, Neri Oxman élabore des matériaux hybrides, conçus à partir de composants moléculaires que l’on trouve dans les arbres, les insectes ou dans les os, qui pourraient être contrôlés numériquement. Ses recherches portent sur de nouveaux matériaux, susceptibles de répondre aux stimuli environnementaux, dans une interaction avec l’environnement physique, lumineux, thermique. »


Un urbanisme inspiré d’une mousse primitive
« Le Physarium polycephalumAppelé de façon courante « blob » est un des plus anciens micro-organismes. Cet organisme unicellulaire, issu de la mousse des forêts, présente des capacités d’apprentissage et de transmission d’informations, qui pourraient demain nous servir pour concevoir des projets d’urbanisme ou résoudre des problèmes de sécheresse. Les réseaux générés par le Physarum démontrent une véritable capacité d’ingénierie. Le Physarum est considéré comme une ‘‘forme d’intelligence primitive’’ : il se déplace, s’auto-régénère, se repère dans un labyrinthe, se souvient et est doté d’anticipation. Il choisit sa nourriture, comme le montrèrent les incroyables recherches de l’éthologue et docteure en comportement animal, Audrey Dussutour au CNRS à Toulouse.
Les architectes EcologicStudio (Claudia Pasquero et Marco Poletto), dans le cadre du Synthetic Landscape Lab, UIBK / Urban Morphogenesis Lab, de l’UCL, à Londres, présenteront dans la prochaine exposition de Mutations-Créations, ‘‘Réseaux-mondes’’ (Commissariat : M-A Brayer & O. Zeitoun), en février-mars 2022, au Centre Pompidou, un projet d’urbanisme inédit basé sur une étude du Physarum polycephalum. Leurs projets explorent une réalité post-anthropocène, où l’impact n’est plus seulement celui de l’homme, mais celui de l’Intelligence artificielle et des systèmes intelligents, issus de la nature. Ce projet, intitulé GAN-Physarum : la Dérive numérique est basé sur un algorithme bio-numérique. Dans ce projet, une bio-peinture intègre un Physarum vivant qui évolue sur la cartographie d’une ville comme un cerveau ‘‘biotechnologique’’. Ce projet se fonde pour ces architectes sur ‘‘l’interdépendance de l’intelligence biologique et numérique’’. Le GAN (Generative Adversarial Networks), algorithme qui est une forme d’intelligence artificielle, se comportera comme un Physarum Polycephalum, démontrant des parallèles entre la croissance de villes et celles d’organismes vivants. Il est avéré que les réseaux de transports sont des ‘‘systèmes à la fois biologiques et urbains’’. Ici cet organisme primitif est utilisé pour une ‘‘re-métabolisation’’ de la ville visant à la neutralité carbone ainsi que pour accroître la biodiversité. »
Responsables du projet : Dr Claudia Pasquero, Dr Marco Poletto / Équipe du projet : Lixi Zhu, Xiaomeng Kong, Konstantinos Alexopoulos, Eirini Alexopoulos, Eirini Tsomokou, Michael Brewster

Image de couverture : The Mediated Matter Group et Neri Oxman, The Aguahoja Artifacts Display
Ce catalogue de matières expérimentales (fabriquées à partir de matières organiques et imprimées par un robot) couvrent quatre années de recherche et révèlent la diversité des esthétiques et des propriétés générées en fonction des géométries, de la distribution des bio-composites et des paramètres de fabrication.
Bibliographie
- [1] M.-A. Brayer, O. Zeitoun (dir.), La Fabrique du vivant, éd. HYX & éd. du Centre Pompidou, 2019.
- [2] Responsables du projet : Dr Claudia Pasquero, Dr Marco Poletto / Équipe du projet : Lixi Zhu, Xiaomeng Kong, Konstantinos Alexopoulos, Eirini Alexopoulos, Eirini Tsomokou, Michael Brewster
- [3] Appelé de façon courante « blob »





